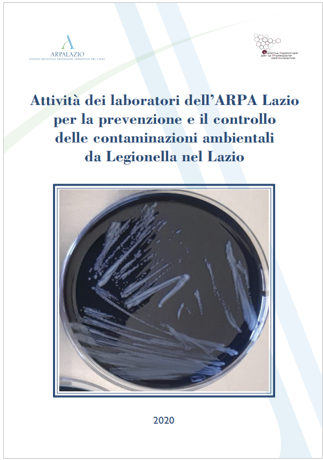
Arpa Lazio report legionellosi

Report Attività ARPA Lazio controllo contaminazioni da legionellosi
| ID 11536 | | Visite: 2598 | Documenti Sicurezza Enti | Permalink: https://www.certifico.com/id/11536 |
Report Attività ARPA Lazio controllo contaminazioni da legionellosi
ARPA Lazio, 09.09.2020
Report di Arpa Lazio sulle attività dei laboratori dell’agenzia per la prevenzione ed il controllo delle contaminazioni da legionellosi.
I laboratori dell’ARPA Lazio svolgono attività tecnico-analitica su tutto il territorio regionale, principalmente a supporto dei Dipartimenti di prevenzione delle ASL nell’ambito delle loro attività di vigilanza, di controllo a seguito della notifica di casi di polmonite da Legionella e nell’ambito del monitoraggio in ambienti di vita per la valutazione del rischio.
Nel report viene proposta una sintesi delle attività analitiche e degli esiti della ricerca ambientale della Legionella per l’anno 2019.
I dati mostrano la distribuzione dei controlli sul territorio regionale con particolare attenzione alla provincia di Roma e in diverse tipologie di siti, la maggior parte dei quali individuati nel corso delle indagini epidemiologiche effettuate dalle ASL, raggruppati in strutture sanitarie, strutture ricettive, ambienti di vita comunitaria e abitazioni private.
I dati evidenziano, nel caso di positività dei campioni, la presenza, in prevalenza, di Legionella pneumophila appartenente al sierogruppo 2-14.
...
Fonte: SNPA
Collegati:
Linee guida prevenzione e controllo legionellosi
Il rischio di esposizione a Legionella spp. in ambienti di vita e di lavoro
Tags: Sicurezza lavoro